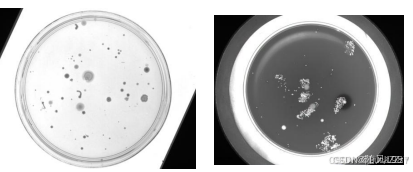

硬件-光源解析
作用:
光源是影响机器视觉图像质量的重要因素.
不同光源将直接影响图像的成像质 量和效果 ,光源对输入数据的影响至少占到 30 %
选择合适的光源,可突显良好的 图像特征点,可以简化算法,提高检测精度、保证检测系统的稳定性
由下图可见
不同的光源产生了完全不同的成像效果,从而也导致不同的检测算
光源的需求分析 :
任务:识别、测量、定位、条形码、字符识别、三维扫描等。
性能要求:如检测内容、检测速度、检测精度等。
其他配合:如相机、镜头、软件、安装方式等
光源颜色:

各种灯管或灯泡会发出各种不同的光色,这些不同的光色由光谱组合而成;
再有就是光照度,有的灯管或灯泡发出的光亮度弱,有的光亮度强,这些都是由灯管或灯泡发出的光能量决定的

人眼可以感知的光电磁波的频率在380 ~ 750THz(太赫兹),波长在780ÿ








 最低0.47元/天 解锁文章
最低0.47元/天 解锁文章

















 833
833

 被折叠的 条评论
为什么被折叠?
被折叠的 条评论
为什么被折叠?








